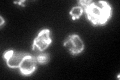
YOR176W
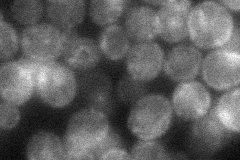
YOR176W
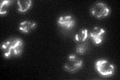
YOR176W

View description
Ferrochelatase, a mitochondrial inner membrane protein, catalyzes the insertion of ferrous iron into protoporphyrin IX, the eighth and final step in the heme biosynthetic pathway
Localization:
Intensity:
Fold change:
Significance:
-
C’ GFP library in SD
mitochondria66.97 -
N' NOP1pr-GFP in SD

mitochondria190.559 -
N' TEF2pr-mCherry in SD

mitochondria206.264 -
N' NATIVEpr-GFP in SD
cell periphery,punctate34.4488 -
N' TEF2pr-VC and Cyto-VN in SD

#N/A0 -
C’ GFP library in SD+DTT

mitochondria91.581.36Yes -
C’ GFP library in SD+H2O2

mitochondria75.911.13No -
C’ GFP library in Starvation Media
mitochondria94.651.41Yes -
C’ GFP library on the background of Pup2-DaMP

mitochondria -
C’ GFP library on the background of CCT mutant

mitochondria61.1610.913154No
